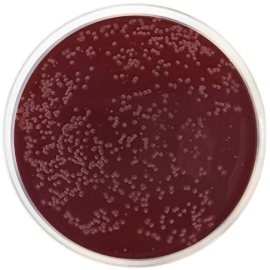
main product photo

Close
CAMPYLOBACTER AGAR BASE (PRESTON) 500 grams/bottle
SKU
CDL/1131
Brand
CONDALAB
Pre-order (Deliver in 8 to 12 weeks)
Campylobacter Agar Base (Preston) is based on the formulation described by Bolton and Robertson, and designed for the isolation of Campylobacter species from human, animal, bird and environmental samples. The supplement is especially selective for Campylobacter jejuni and C. coli. The recovery of injured cells can be improved by preenrichment in broth medium, permitting sublethally injured organisms to repair lesions and to tolerate certain selective antibiotics.
Campylobacter spp. are of worldwide significance in human and animal disease, especially C. jejuni, considered one of the main causes of acute bacterial diarrhea in man.
Casein peptone and Soy peptone provide nitrogen, vitamins, minerals and amino acids essential for growth. Sodium chloride supplies essential electrolytes for transport and osmotic balance. Polymyxin B inhibits Gram-negative microorganisms. Cycloheximide inhibits yeasts. Rifampicin inhibits Gram-positive organisms. Trimethoprim exerts its antibacterial action through the selective inhibition of bacterial dihydrofolate reductase (DHFR), which is an essential enzyme in all living cells. Bacteriological agar is the solidifying agent.
Campylobacter Agar Base (Preston) is based on the formulation described by Bolton and Robertson, and designed for the isolation of Campylobacter species from human, animal, bird and environmental samples. The supplement is especially selective for Campylobacter jejuni and C. coli. The recovery of injured cells can be improved by preenrichment in broth medium, permitting sublethally injured organisms to repair lesions and to tolerate certain selective antibiotics.
Campylobacter spp. are of worldwide significance in human and animal disease, especially C. jejuni, considered one of the main causes of acute bacterial diarrhea in man.
Casein peptone and Soy peptone provide nitrogen, vitamins, minerals and amino acids essential for growth. Sodium chloride supplies essential electrolytes for transport and osmotic balance. Polymyxin B inhibits Gram-negative microorganisms. Cycloheximide inhibits yeasts. Rifampicin inhibits Gram-positive organisms. Trimethoprim exerts its antibacterial action through the selective inhibition of bacterial dihydrofolate reductase (DHFR), which is an essential enzyme in all living cells. Bacteriological agar is the solidifying agent.
| Brand | CONDALAB |
|---|
Write Your Own Review

Validate your login